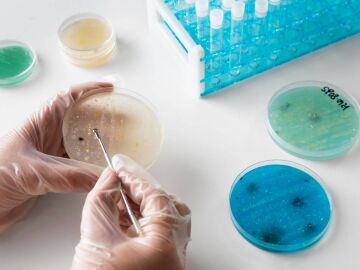
Aumento del c&aacute;ncer colorrectal en j&oacute;venes

Astronomía, divulgación, descubrimientos, ecología, innovación...

Red Eléctrica descarta por el momento un ciberataque como causa del apagón

El apagón eléctrico activa una ola de bulos y desinformaciones

La nube Eos cercana a la Tierra amplía lo que se sabe del espacio interestelar

Los ataques de tiburón podrían ser en defensa propia y no agresiones planificadas

El sarampión, la rubeola y la polio podrían volver a Estados Unidos

Emplean fibra óptica para monitorizar la actividad de volcanes en Islandia

Las hembras de bonobos controlan a los machos a través de la sororidad

España anuncia 800 millones para su primera Estrategia de Tecnologías Cuánticas

La civilización púnica fue la primera verdaderamente cosmopolita

La dopamina ayuda a evitar experiencias negativas, según un estudio